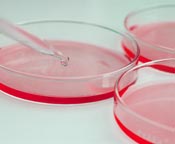

|
 |
|
• |
Easy sterility |
• |
Very gentle mixing with new Fishtail stirrer |
• |
Adapter for very sensitive cells |
• |
Radiation heating |
• |
Culture volumes from 35 ml to 6000 ml |
• |
MINIFOR is very compact |
• |
Fastest set up |
• |
Fully automatic gas flow |
• |
Automatic pH and pO2 control |
• |
Self-cleaning gas microsparger |
• |
Continuous culture |
• |
INTEGRATOR |
• |
PC control |
|
All these features result in a dramatic improvement of the cell culture, precise control of preset parameters and their easy documentation. |
|
 |
| |
• |
The Minifor was developed as a result of the need to construct a small laboratory fermentor for volumes from 0.035 to 4.5l. |
• |
Based on long personal practical experience in fermentation we wanted to create a laboratory fermentor, which was easy to use and with the capacity to measure and control all the important parameters of the biological culture. |
• |
The fermentor had to take up minimum space on the bench but with a good access to all parts. |
• |
Several laboratory fermentors should, when placed side by side be suitable for the optimisation of the parameters of growth of culture or optimisation of biotransformations etc. |
• |
Each fermentor should be able to work independently or be connected to a PC for advanced regulation and extensive data treatment. |
|
|
|
 |
|
• |
Collects fractions in any racks of your choice |
• |
Collects unlimited number of fractions |
• |
The electronics and moving parts are placed above the tubes
– No damage due to spilling |
• |
Can be placed in a cold bath or any other thermo-stabilized container |
• |
Unlimited number of programmes |
• |
Extremely easy programming of rack and tube position by means of a white pen |
• |
Fractionation according to time (0.1–999.9 min and 1–9999 min) or volume (0.05–500 ml or 0.1 to 30 l) |
• |
Good quality for a fair price |
• |
Solvent resistant construction |
• |
Tubes easily accessible from all sides |
• |
Pause (from 0 to 999.9 min and 1 to 9999 min) or rinsing can be programmed between fractions |
• |
Up to 18 fractions simultaneously; multi-channel operation (optional) |
• |
Collection in lines or zigzag (meander like) |
• |
RS-232 interface (optional) |
|
 |
|
• |
Practical, precise and reliable pumps - the most compact in their class. |
• |
Flow rates from 0.01 to 10’000 ml/hour |
• |
Large digital speed setting range from 0 to 999 |
• |
New motor technology |
• |
Extensive remote controls |
• |
Greatly extended tubing life with decreased pulsation |
• |
Flow rate programming (up to 99 steps) and
automatic switch-on and -off without using any timer |
• |
Very economic in use; virtually noiseless operation |
• |
Most compact pump of this type on the market |
• |
Access to reaction kinetics by using the Pump-Flow INTEGRATOR |
• |
Low voltage plug-in power supply for maximum safety |
• |
RS-485 interface (optional) |
• |
Control software PNet (optional) |
|
|
|
The special mechanics of LAMBDA peristaltic pumps has been developed because no pump could be used for continuous fermentation lasting up to eight weeks. |
|
 |
|
• |
New syringe fixing system “VIT-FIT” allows almost any syringe to be used without adapter (from micro-syringes to large volume syringes of 150 ml and more) |
• |
The syringe is tightly held in both directions – infusion and filling |
• |
Highest mechanical stability allows for high pumping forces and precise flow rates without pulsation |
• |
Programmable (99 steps for infusion and filling) |
• |
Very easy handling of the syringes |
• |
Swiss quality motor and ball screws |
• |
Two valve outputs |
• |
Remote controls |
• |
RS-485 interface (optional) |
• |
Control software PNet (optional) |
|
 |
|
• |
For automatic or continuous addition of solids, powders, crystalline substances, nano-materials and nano powders without a spoon |
• |
Dosing speed range from 0 to 999 |
• |
Reproducible dosing flow rates (e.g.
50 mg/min to 50 g/min for NaCl) |
• |
Programmable |
• |
Easy assembly and cleaning |
• |
Necessary to comply with GLP requirements and safety standards |
• |
Hermetic construction allows operation in controlled atmospheres (Ar, N2,…) |
• |
Safe handling of dangerous and toxic substances |
• |
Remote controls
|
• |
RS-485 interface (optional) |
• |
Control software PNet (optional) |
|
 |
|
• |
Allows the control of pH of cell cultures by controlled addition of gaseous CO2, N2
or any other gas with a suitable controller |
• |
High-quality laminar mass flow sensor with minimal pressure drop |
• |
Can be used independently - all functions accessible from the front panel |
• |
Flow rates from 0 – 500 ml/min or 0 – 5 l/min |
• |
Flow rate regulated by a proprietary proportional
needle valve controlled by a microprocessor |
• |
Linearity error less than ± 3 % reading (which is
much better than precision expressed as percent of full scale used by some producers) |
• |
Repeatability better than ± 0.5% reading |
• |
Programmable flow rates |
• |
Flow volume can be recorded with INTEGRATOR |
• |
RS-485 interface (optional) |
• |
Control software PNet (optional) |
|
 |
|
• |
Control of pH during chemical reactions where the pH is controlled by addition of acid or base
(hydrolysis of esters, amides, anhydrides etc.) |
• |
Measurements of enzyme activities of numerous
enzymes (esterases, acylases, lipases, proteases
and others using a pH-stat) |
• |
Control and quantification of metabolical activity of cells during fermentations and cell-cultures (by
control of pH, rH, pO2, pCO2, conductivity or other required parameter) |
• |
Recording of foam formation (automatic addition of antifoam agent) |
• |
Recording of addition of reactives during exothermic reactions with addition of reactive controlled by a thermostat |
• |
Recording of consumption of reactives during titration making of gradient for gels, chromatography etc. |
|